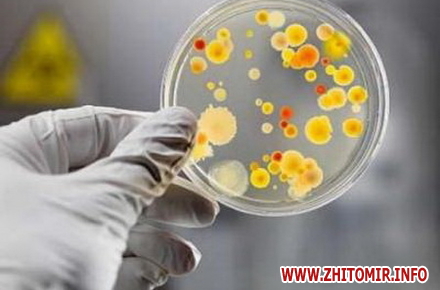

У 11 дітей з Олевського району Житомирської області, які захворіли на гостру кишкову інфекцію після виїзної екскурсії, підозрюють сальмонельоз.
Про це йдеться у повідомленні головного управління Держсанепідслужби Житомирської області.
«Станом на 07.06.2015 року в інфекційне відділення Олевської ЦРЛ з різних населених пунктів району звернулось за медичною допомогою 11 дітей віком від 7 до 16 років з діагнозом «гостра кишкова інфекція, сальмонельоз?». Всі захворілі в складі групи, що складала 66 дітей та 10 дорослих, знаходились в триденній екскурсії по Київщині. Під час подорожі в різних умовах вживались харчові продукти як домашнього виготовлення, так і придбані в торгівельній мережі», - йдеться у повідомленні.
Як уточнив Житомир.info заступник начальника ГУ Держсанепідслужби Житомирської області Іван Киричук, діагноз іще не підтверджений, оскільки процес дослідження зразків біоматеріалів хворих дітей ще триває.
У домашніх вогнищах учасників екскурсії, які захворіли, проводяться протиепідемічні заходи, - повідомляє прес-служба.
Як повідомляв Житомир.info, після екскурсії Київщиною з харчовим отруєнням в лікарні опинилися 10 дітей віком від 7 до 16 років.
За інформацією головного лікаря Олевської центральної районної лікарні Павла Демковича, станом на 6 червня одну дитину з числа госпіталізованих перевели на лікування до обласної лікарні, у інших нормалізувалася температура.
























